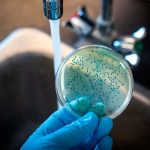
«Chiva» se desatan bacterias carnívoras en Estados Unidos Foto: Bacterias en EE.UU. /cortesía

Etiqueta: enfermedades
«Chiva» se desatan bacterias carnívoras en Estados Unidos
Un estudio científico, realizado por investigadores de varias instituciones de Estados Unidos, detectó varias especies de bacterias patógenas; algunas de ellas carnívoras, en muestras...
¡Cuidado la diabetes! OMS aconseja no usar edulcorantes artificiales
La Organización Mundial de la Salud (OMS), emitió una advertencia sobre los edulcorantes artificiales, esos omnipresentes sustitutos del azúcar. Asimismo, afirmando que no ayudan...
Arranca en Nicaragua Campaña Nacional de Vacunación contra 17 enfermedades
La Campaña Nacional de Vacunación, 'Vida, Salud y Fuerzas', inició en toda Nicaragua, para combatir 17 enfermedades que podrían llegar a ser mortales.
Comenzó con...
¡Por estas razones no debes prestar tus audífonos!
Desde hace algunos años los audífonos inalámbricos han ganado una gran popularidad entre personas de todas las edades; pues estos dispositivos permiten escuchar música...
Conocé las 4 enfermedades que se pueden detectar a través de los ojos
La vista (ojos), es sin duda una parte fundamental para la salud, ya que por medio de ellos se reciben los estímulos que el...
¡Impresionante! Inodoro electrónico es capaz de detectar males gastrointestinales
Es interesante cómo la tecnología avanza con el pasar del tiempo. Un inodoro es capaz de detectar si padeces de enfermedades gastrointestinales.
Y es que...
Conoce las 4 enfermedades relacionadas con las cucarachas que «causan alertas»
¿Sabías que existen cuatro enfermedades relacionadas con las cucarachas que causan preocupación? Seguramente no, pero la plaga de estos insectos deben ser tomados como...
Nueva tecnología: Grabarte en el baño para detectar enfermedades intestinales
Una inteligencia artificial podría detectar enfermedades intestinales, con tan solo grabar las defecaciones. Para ello habría que instalar una grabadora en el baño para...
Ojo: Estas son las enfermedades raras que te pueden afectar
Estas son algunas de las enfermedades más raras según la OMS, donde menciona que estas se presentan en cada 5 personas entre 10 mil.
Así...
¿Ya conocés sobre los picos de glucosa y sus síntomas?, Aquí te contamos
La glucosa es la principal fuente de energía del cuerpo. Hay una hormona que se llama insulina; y ayuda a que la glucosa pase...